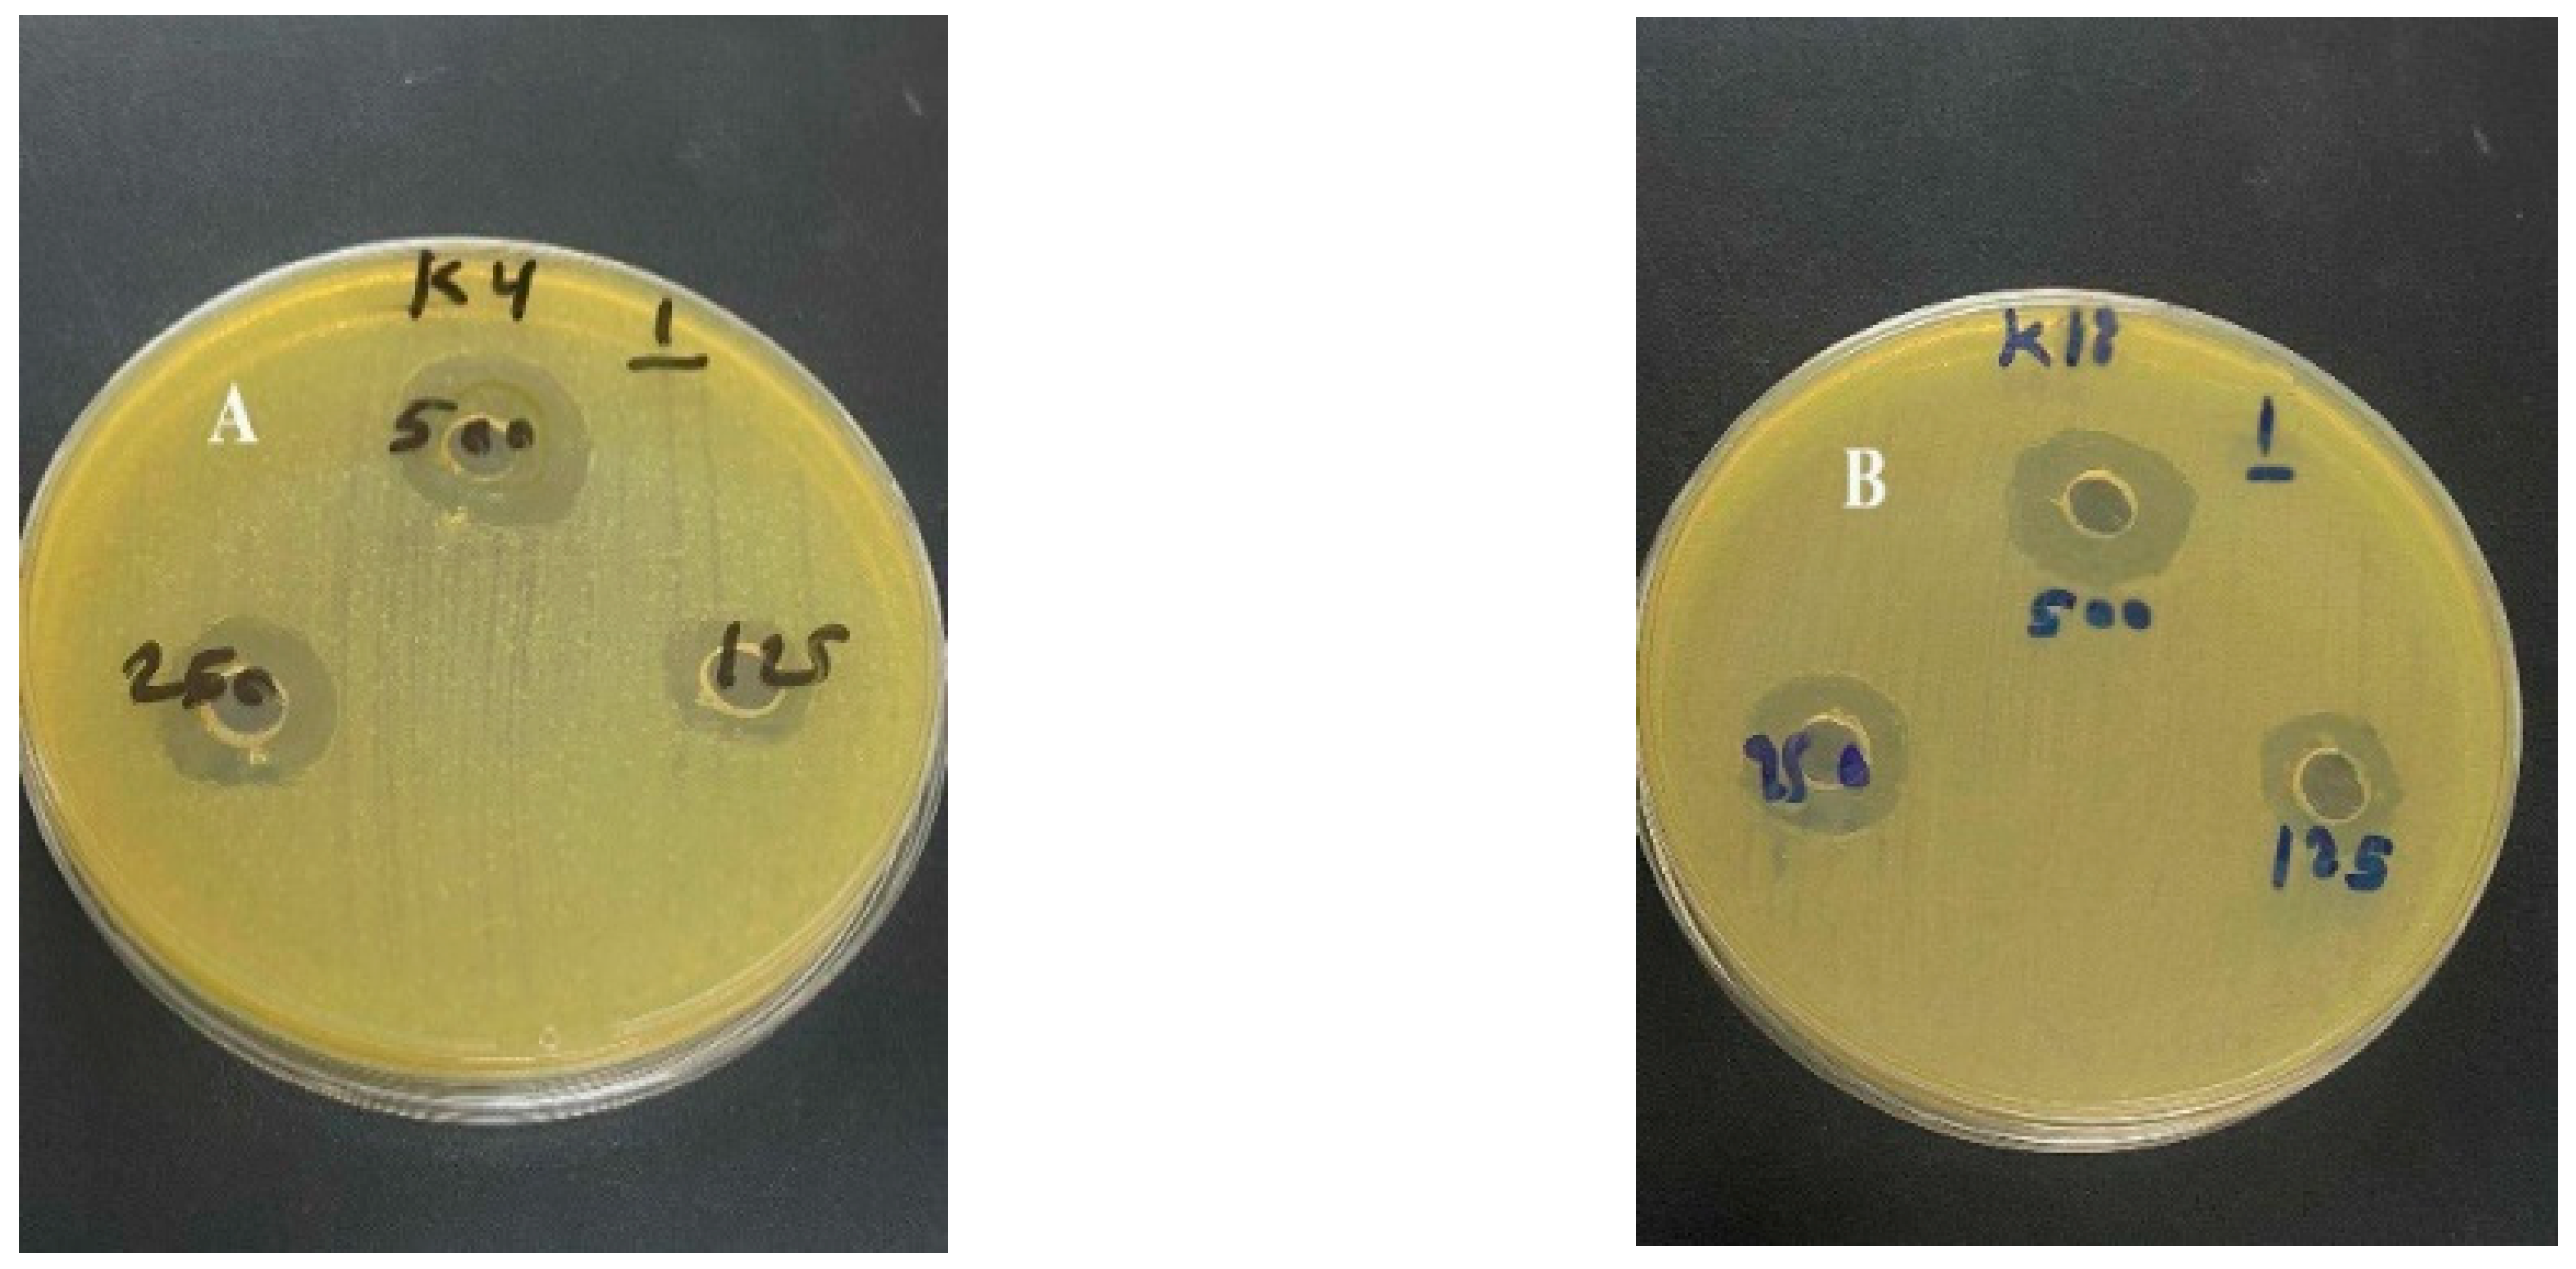

Emerging Resistance in Klebsiella pneumoniae: CTX-M Prevalence, Biofilm Formation, and Efficacy of Platanus orientalis Extract
Abstract
1. Introduction
2. Materials and Methods
- Ethics Statement:
2.1. Collection of Samples and Bacterial Identification
2.2. Antibiotic Susceptibility Test of Clinical Isolate
2.3. Molecular Analysis of CTX-M ESBL Genes in Klebsiella Pneumoniae Isolates
2.4. Extraction and Antimicrobial Activity of Leaves of Platanus orientalis Linn
2.5. Phytochemical Screening of Platanus orientalis Linn Leaves Extract
2.6. MIC of Platanus orientalis Linn Leave Extract
2.7. Biofilm Formation
2.8. Antibiofilm Formation
2.9. Statistical Analysis
3. Results
3.1. Isolation and Identification of Bacteria
3.2. Antibiotic Susceptibility
3.3. ESBL Characterization
3.4. Methanolic Extract’s Antibacterial Activity
3.5. Phytochemical Screening of Platanus orientalis Linn Leaves Extract
3.6. Biofilm and Anti-Biofilm Assays
3.7. Relationship Between CTX-M Production and Biofilm Formation
4. Discussion
5. Conclusions
Author Contributions
Funding
Institutional Review Board Statement
Conflicts of Interest
References
- Hu, Y.; Anes, J.; Devineau, S.; Fanning, S. Klebsiella pneumoniae: Prevalence, Reservoirs, Antimicrobial Resistance, Pathogenicity, and Infection: A Hitherto Unrecognized Zoonotic Bacterium. Foodborne Pathog. Dis. 2020, 18, 63–84. [Google Scholar] [CrossRef]
- Liu, X.; Sai, F.; Li, L.; Zhu, C.; Huang, H. Clinical characteristics and risk factors of catheter-associated urinary tract infections caused by Klebsiella pneumoniae. Ann. Palliat. Med. 2020, 9, 2668–2677. [Google Scholar] [CrossRef]
- Shariati, A.; Moradabadi, A.; Ghaznavi-Rad, E.; Dadmanesh, M.; Komijani, M.; Nojoomi, F. Investigation into antibacterial and wound healing properties of platelets lysate against Acinetobacter baumannii and Klebsiella pneumoniae burn wound infections. Ann. Clin. Microbiol. Antimicrob. 2021, 20, 40. [Google Scholar] [CrossRef]
- Parrott, A.M.; Shi, J.; Aaron, J.; Green, D.A.; Whittier, S.; Wu, F. Detection of multiple hypervirulent Klebsiella pneumoniae strains in a New York City hospital through screening of virulence genes. Clin. Microbiol. Infect. 2020, 27, 583–589. [Google Scholar] [CrossRef]
- Mohammed, A.N.; Al–Rawi, D.F.; Buniya, H.K. Evaluation of Antibiotic Resistance of Klebsiella pneumoniae Isolated from Patients in Hospitals in Iraq. Acta Microbiol. Bulg. 2023, 39, 411–417. [Google Scholar] [CrossRef]
- Bjarnsholt, T.; Buhlin, K.; Dufrêne, Y.F.; Gomelsky, M.; Moroni, A.; Ramstedt, M.; Rumbaugh, K.P.; Schulte, T.; Sun, L.; Åkerlund, B.; et al. Biofilm formation—What we can learn from recent developments. J. Intern. Med. 2018, 284, 332–345. [Google Scholar] [CrossRef] [PubMed]
- Sawa, T.; Kooguchi, K.; Moriyama, K. Molecular diversity of extended-spectrum β-lactamases and carbapenemases, and antimicrobial resistance. J. Intensive Care 2020, 8, 13. [Google Scholar] [CrossRef] [PubMed]
- Cantón, R.; González-Alba, J.M.; Galán, J.C. CTX-M Enzymes: Origin and diffusion. Front. Microbiol. 2012, 3, 110. [Google Scholar] [CrossRef]
- Reuter, J.; Merfort, I.; Wölfle, U.; Seelinger, G.; Schempp, C.M. Botanicals in dermatology and skin health. In Botanical Medicine: From Bench to Bedside; Mary Ann Liebert: New Rochelle, NY, USA, 2009; pp. 33–65. [Google Scholar]
- Zhao, W.-H.; Hu, Z.-Q. Epidemiology and genetics of CTX-M extended-spectrum β-lactamases in Gram-negative bacteria. Crit. Rev. Microbiol. 2012, 39, 79–101. [Google Scholar] [CrossRef]
- Maslova, E.; Eisaiankhongi, L.; Sjöberg, F.; McCarthy, R.R. Burns and biofilms: Priority pathogens and in vivo models. npj Biofilms Microbiomes 2021, 7, 73. [Google Scholar] [CrossRef]
- Dan, B.; Dai, H.; Zhou, D.; Tong, H.; Zhu, M. Relationship between drug resistance characteristics and biofilm formation in Klebsiella pneumoniae strains. Infect. Drug Resist. 2023, 16, 985–998. [Google Scholar] [CrossRef]
- Lupo, A.; Papp-Wallace, K.M.; Bonomo, R.A.; Endimiani, A. Non-Phenotypic tests to detect and characterize antibiotic resistance mechanisms in enterobacteriaceae. In Antimicrobial Resistance and Food Safety: Methods and Techniques; Academic Press: Cambridge, MA, USA, 2015; pp. 233–257. [Google Scholar] [CrossRef]
- Pazyar, N.; Yaghoobi, R.; Rafiee, E.; Mehrabian, A.; Feily, A. Skin Wound Healing and Phytomedicine: A review. Ski. Pharmacol. Physiol. 2014, 27, 303–310. [Google Scholar] [CrossRef]
- Khan, A.S. Woody Plants with Possible Anti-HIV Activity. In Medicinally Important Trees; Springer: Berlin/Heidelberg, Germany, 2017; pp. 109–131. [Google Scholar] [CrossRef]
- Carpenter, R.J.; Hill, R.S.; Jordan, G.J. Leaf cuticular morphology links Platanaceae and proteaceae. Int. J. Plant Sci. 2005, 166, 843–855. [Google Scholar] [CrossRef]
- Khalid, N. Internal Structure of Platanus (Platanus orientalis L.) Grown in Different Environments. Egypt. J. Agric. Res. 2024, 102, 103–114. [Google Scholar] [CrossRef]
- Shende, S.; Joshi, K.A.; Kulkarni, A.S.; Charolkar, C.; Shinde, V.S.; Parihar, V.S.; Kitture, R.; Banerjee, K.; Kamble, N.; Bellare, J.; et al. Platanus orientalis Leaf Mediated Rapid Synthesis of Catalytic Gold and Silver Nanoparticles. J. Nanomed. Nanotechnol. 2018, 9, 1000494. [Google Scholar] [CrossRef]
- Dogan, A.; Anuk, O.O. Investigation of the phytochemical composition and antioxidant properties of chinar (Platanus orientalis L.) leaf infusion against ethanol-induced oxidative stress in rats. Mol. Biol. Rep. 2019, 46, 3049–3061. [Google Scholar] [CrossRef] [PubMed]
- Asadbeigi, M.; Mohammadi, T.; Rafieian-Kopaei, M.; Saki, K.; Bahmani, M.; Delfan, M. Traditional effects of medicinal plants in the treatment of respiratory diseases and disorders: An ethnobotanical study in the Urmia. Asian Pac. J. Trop. Med. 2014, 7, S364–S368. [Google Scholar] [CrossRef] [PubMed]
- Niknam, S.; Rastegari, A.; Bozorgi, M.; Vahedi-Mazdabadi, Y.; Saeedi, M.; Akbarzadeh, T. In vivo evaluation of wound healing properties of Platanus orientalis L. Pharm. Sci. 2021, 28, 275–284. [Google Scholar] [CrossRef]
- Weinstein, M.P.; Lewis, J.S. The Clinical and Laboratory Standards Institute Subcommittee on Antimicrobial Susceptibility Testing: Background, organization, Functions, and Processes. J. Clin. Microbiol. 2020, 58, 10–1128. [Google Scholar] [CrossRef]
- Paulin-Curlee, G.G.; Singer, R.S.; Sreevatsan, S.; Isaacson, R.; Reneau, J.; Foster, D.; Bey, R. Genetic Diversity of Mastitis-Associated Klebsiella pneumoniae in Dairy Cows. J. Dairy. Sci. 2007, 90, 3681–3689. [Google Scholar] [CrossRef]
- Magiorakos, A.-P.; Srinivasan, A.; Carey, R.B.; Carmeli, Y.; Falagas, M.E.; Giske, C.G.; Harbarth, S.; Hindler, J.F.; Kahlmeter, G.; Olsson-Liljequist, B.; et al. Multidrug-resistant, extensively drug-resistant and pandrug-resistant bacteria: An international expert proposal for interim standard definitions for acquired resistance. Clin. Microbiol. Infect. 2011, 18, 268–281. [Google Scholar] [CrossRef]
- Townsend, C.C. Flora of Iraq; Ministry of Agriculture, Republic of Iraq: Baghdad, Iraq, 1966; Volume 1–9. [Google Scholar]
- López-Bascón, M.A.; De Castro, M.D.L. Soxhlet Extraction. In Liquid-Phase Extraction; Elsevier: Amsterdam, The Netherlands, 2019; pp. 327–354. [Google Scholar] [CrossRef]
- Loustau, E.; Rols, J.-L.; Leflaive, J.; Marcato-Romain, C.-E.; Girbal-Neuhauser, E. Comparison of extraction methods for the characterization of extracellular polymeric substances from aggregates of three biofilm-forming phototrophic microorganisms. Can. J. Microbiol. 2018, 64, 887–899. [Google Scholar] [CrossRef]
- Gokhale, M.S. Pharmacognosy; Pragati Books Pvt. Ltd.: Pune, India, 2008. [Google Scholar]
- Ohikhena, F.U.; Wintola, O.A.; Afolayan, A.J. Evaluation of the Antibacterial and Antifungal Properties of Phragmanthera capitata (Sprengel) Balle (Loranthaceae), a Mistletoe Growing on Rubber Tree, Using the Dilution Techniques. Sci. World J. 2017, 2017, 1–8. [Google Scholar] [CrossRef] [PubMed]
- Yang, Y.; Hwang, E.-H.; Park, B.-I.; Choi, N.-Y.; Kim, K.-J.; You, Y.-O. Artemisia princepsInhibits Growth, Biofilm Formation, and Virulence Factor Expression ofStreptococcus mutans. J. Med. Food 2019, 22, 623–630. [Google Scholar] [CrossRef]
- Adeosun, I.J.; Baloyi, I.T.; Cosa, S. Anti-Biofilm and Associated Anti-Virulence Activities of Selected Phytochemical Compounds against Klebsiella pneumoniae. Plants 2022, 11, 1429. [Google Scholar] [CrossRef]
- Ahmed, H.J.; Ganjo, A.R. Detection of Carbapenemase-Producing Klebsiella pneumoniae and Escherichia coli Recovered from Clinical Specimens in Erbil City Kurdistan Region of Iraq. Al-Mustansiriyah J. Sci. 2019, 30, 10–18. [Google Scholar] [CrossRef]
- Raouf, F.E.A.; Benyagoub, E.; Alkhudhairy, M.K.; Akrami, S.; Saki, M. Extended-spectrum beta-lactamases among Klebsiella pneumoniae from Iraqi patients with community-acquired pneumonia. Rev. Da Assoc. Médica Bras. 2022, 68, 833–837. [Google Scholar] [CrossRef]
- Abayneh, M.; Tesfaw, G.; Abdissa, A. Isolation of Extended-Spectrum β-lactamase- (ESBL-) Producing Escherichia coli and Klebsiella pneumoniae from Patients with Community-Onset Urinary Tract Infections in Jimma University Specialized Hospital, Southwest Ethiopia. Can. J. Infect. Dis. Med. Microbiol. 2018, 2018, 4846159. [Google Scholar] [CrossRef] [PubMed]
- Nerurkar, A.; Solanky, P.; Naik, S.S. Bacterial pathogens in urinary tract infection and antibiotic susceptibility pattern. J. Pharm. Biomed. Sci. 2012, 21, 1–3. [Google Scholar]
- Jean, S.-S.; Chang, Y.-C.; Lin, W.-C.; Lee, W.-S.; Hsueh, P.-R.; Hsu, C.-W. Epidemiology, Treatment, and prevention of nosocomial bacterial pneumonia. J. Clin. Med. 2020, 9, 275. [Google Scholar] [CrossRef]
- Al-Hamed, Z.A.A.; Al-Mayahi, F.S.A. Antibiogram of Klebsiella pneumoniae that isolated from clinical and environmental samples in Al-Diwaniyah hospitals. Al-Qadisiyah J. Pure Sci. 2021, 26, 44–54. [Google Scholar] [CrossRef]
- Susethira, A.R.; Uma, A. Prevalence of klebsiella bacteriuria and antimicrobial susceptibility in a tertiary care hospital, Tiruchirapalli, India. Int. J. Pharm. Chem. Res. 2016, 8, 538–542. [Google Scholar]
- Abbas, F.M. Molecular detection of CTX-M extended spectrum beta-lactamase among carbapenem—Resistant Klebsiella pneumoniae from Al-Hillah Teaching Hospital environment, Babylon Province, Iraq. J. Phys. Conf. Ser. 2019, 1294, 062044. [Google Scholar] [CrossRef]
- Hussein, N.H.; Kareem, S.M.; Al-Kakei, S.N.H.; Taha, B.M. The predominance of Klebsiella pneumoniae carbapenemase (KPC-type) gene among high-level carbapenem-resistant Klebsiella pneumoniae isolates in Baghdad, Iraq. Mol. Biol. Rep. 2022, 49, 4653–4658. [Google Scholar] [CrossRef]
- Shabaa, R.A.H. Detection of CTX-M-1 gene Among Klebsiella pneumonia Isolates in An Najaf Province. Iraqi J. Biotechnol. 2014, 13, 128–133. [Google Scholar]
- Abed, A.N.; Ahmed, O.; Abdulmajeed, M.; Khazaal, Y.M. Evaluate Multi-Drug Resistance Pattern of Microbial Flora from Hospital Premises of Baghdad Hospitals. Teikyo Med. J. 2021, 44, 2461–2466. [Google Scholar]
- Awoke, T.; Teka, B.; Seman, A.; Sebre, S.; Yeshitela, B.; Aseffa, A.; Mihret, A.; Abebe, T. High Prevalence of Multidrug-Resistant Klebsiella pneumoniae in a Tertiary Care Hospital in Ethiopia. Antibiotics 2021, 10, 1007. [Google Scholar] [CrossRef]
- Narjes, M.B.; Keyvani, H.; Zargar, M.; Talebi, M.; Zolfaghari, M.R. Epidemiological and Genetic Overview of the Klebsiella pneumoniae Carbapenemases (KPCs) in K. pneumoniae Isolated from the Clinical Samples in Iran. Int. J. Adv. Biol. Biomed. Res. 2019, 8, 75–85. [Google Scholar] [CrossRef]
- Mohammed, A.B.; Anwar, K.A. Phenotypic and genotypic detection of extended spectrum beta lactamase enzyme in Klebsiella pneumoniae. PloS ONE 2022, 17, e0267221. [Google Scholar] [CrossRef] [PubMed]
- Van Almsick, V.; Schuler, F.; Mellmann, A.; Schwierzeck, V. The use of Long-Read Sequencing Technologies in infection control: Horizontal transfer of a BLACTX-M-27 containing LNCFII plasmid in a patient screening sample. Microorganisms 2022, 10, 491. [Google Scholar] [CrossRef] [PubMed]
- Poulou, A.; Grivakou, E.; Vrioni, G.; Koumaki, V.; Pittaras, T.; Pournaras, S.; Tsakris, A. Modified CLSI Extended-Spectrum β-Lactamase (ESBL) Confirmatory Test for Phenotypic Detection of ESBLs among Enterobacteriaceae Producing Various β-Lactamases. J. Clin. Microbiol. 2014, 52, 1483–1489. [Google Scholar] [CrossRef] [PubMed]
- Schaufler, K.; Semmler, T.; Wieler, L.H.; Wöhrmann, M.; Baddam, R.; Ahmed, N.; Müller, K.; Kola, A.; Fruth, A.; Ewers, C.; et al. Clonal spread and interspecies transmission of clinically relevant ESBL-producingEscherichia coliof ST410—Another successful pandemic clone? FEMS Microbiol. Ecol. 2015, 92, fiv155. [Google Scholar] [CrossRef] [PubMed]
- Almohana, A.M.; Hadi, Z.J.; Abdul-Hadi, S. Extended spectrum ß-lactamase (ESBL) mediated resistance to third generation cephalosporins in urinary tract infection isolates of Klebseilla pneumonia. Al-Qadisiyah Med. J. 2010, 6, 142–158. [Google Scholar] [CrossRef]
- Tahanasab, Z.; Mobasherizadeh, S.; Moghadampour, M.; Rezaei, A.; Maleki, N.; Faghri, J. High Prevalence of Multiple Drug Resistance among ESBLs-Producing Klebsiella pneumoniae Isolated from Hospitalized Patients in Isfahan, Iran. J. Med. Bacteriol. 2017, 5, 29–38. [Google Scholar]
- Eskandari-Nasab, E.; Moghadampour, M.; Tahmasebi, A. Prevalence of blaCTX-M Gene among Extended- Spectrum β-Lactamases Producing Klebsiella pneumoniae Clinical Isolates in Iran: A Meta-Analysis. Iran. J. Med. Sci. 2017, 43, 347–354. [Google Scholar] [CrossRef]
- Salawudeen, A.; Desa, M.N.M.; Neoh, H.M.; Masri, S.N.; Jamaluddin, T.Z.M.T. Genomic Determinants of Resistance in Extended Spectrum Beta Lactamases (ESBLS) Klebsiella pneumoniae Isolates of a Teaching Hospital in Klang Valley. Int. J. Infect. Dis. 2023, 130, S64. [Google Scholar] [CrossRef]
- Feizabadi, M.M.; Mahamadi-Yeganeh, S.; Mirsalehian, A.; Mirafshar, S.-M.; Mahboobi, M.; Nili, F.; Yadegarinia, D. Genetic characterization of ESBL producing strains of Klebsiella pneumoniae from Tehran hospitals. J. Infect. Dev. Ctries. 2010, 4, 609–615. [Google Scholar] [CrossRef]
- Poovendran, P.; Vidhya, N.; Murugan, S. Antimicrobial susceptibility pattern of ESBL and non-ESBL producing uropathogenic Escherichia coli (UPEC) and their correlation with biofilm formation. Intl J. Microbiol. Res. 2013, 4, 56–63. [Google Scholar]
- Surgers, L.; Boyd, A.; Girard, P.-M.; Arlet, G.; Decré, D. Biofilm formation by ESBL-producing strains of Escherichia coli and Klebsiella pneumoniae. International J. Med. Microbiol. 2018, 309, 13–18. [Google Scholar] [CrossRef]

| Gene Name | Primer Sequence | Fragment Size (pb) | Annealing Temperature |
|---|---|---|---|
| CTX-M | F GCGATGTGCAGCACCAGTAA | 392 | 60 |
| R TTACCCAGCGTCAGATTCCG | |||
| CTX-M-1 | F AAAGTGATGGCCGTGGCC | 522 | 58 |
| R GATATCGTTGGTGGTGCCA | |||
| CTX-M-15 | F CGTCACGCTGTTGTTAGGAA | 781 | 59 |
| R ACGGCTTTCTGCCTTAGGTT | |||
| CTX-M-3 | F AATCACTGCGCCAGTTCACGCT | 479 | 64 |
| R GAACGTTTCGTCTCCCAGCTGT |
| Site of Isolate | Number of Samples | Male | Female | Klebsiella (%) |
|---|---|---|---|---|
| Wound | 65 | 35 | 30 | 2 (8.7%) |
| Stool | 45 | 19 | 26 | 4 (17.4%) |
| Burns | 35 | 18 | 17 | 5 (21.7%) |
| Body Fluids | 20 | 10 | 10 | 0 (0%) |
| Blood | 45 | 23 | 22 | 4 (17.4%) |
| Urine | 40 | 19 | 21 | 5 (21.7%) |
| Water | 18 | ----- | ----- | 2 (8.7%) |
| Soil | 32 | ----- | ----- | 1 (4.3%) |
| Total | 300 | ----- | ----- | 23 (100%) |
| Antibiotics | Resistance, n (100%) | Intermediate, n (100%) | Sensitive, n (100%) |
|---|---|---|---|
| Meropenem | 2 (8.7%) | 1 (4.3%) | 20 (87%) |
| Amikacin | 14 (60.9%) | 5 (21.7%) | 4 (17.4%) |
| Cefotaxime | 23 (100%) | 0 (0.0%) | 0 (0.0%) |
| Amoxicillin | 23 (100%) | 0 (0.0%) | 0 (0.0%) |
| Imipenem | 11 (47.8%) | 10 (43.5%) | 2 (8.7%) |
| Levofloxacin | 23 (100%) | 0 (0.0%) | 0 (0.0%) |
| Gentamicin | 16 (69.6%) | 5 (21.7%) | 2 (8.7%) |
| Ceftazidime | 23 (100%) | 0 (0.0%) | 0 (0.0%) |
| Augmentin | 23 (100%) | 0 (0.0%) | 0 (0.0%) |
| Ceftriaxone | 23 (100%) | 0 (0.0%) | 0 (0.0%) |
| Ciprofloxacin | 22 (95.7%) | 1 (4.3%) | 0 (0.0%) |
| Biofilm Formation Level | Without Extract (%) | With Extract (%) | |
|---|---|---|---|
| 1 | Non-biofilm formation | 4.347826087% | 34.7826086957% |
| 2 | Weak biofilm formation | 47.8260869565% | 65.2173913043% |
| 3 | Moderate biofilm formation | 47.8260869565% | 0.0 |
| 4 | Strong biofilm formation | 0.0 | 0.0 |
Disclaimer/Publisher’s Note: The statements, opinions and data contained in all publications are solely those of the individual author(s) and contributor(s) and not of MDPI and/or the editor(s). MDPI and/or the editor(s) disclaim responsibility for any injury to people or property resulting from any ideas, methods, instructions or products referred to in the content. |
© 2025 by the authors. Licensee MDPI, Basel, Switzerland. This article is an open access article distributed under the terms and conditions of the Creative Commons Attribution (CC BY) license (https://creativecommons.org/licenses/by/4.0/).
Share and Cite
Abed, A.N.; Mnif, B. Emerging Resistance in Klebsiella pneumoniae: CTX-M Prevalence, Biofilm Formation, and Efficacy of Platanus orientalis Extract. Microbiol. Res. 2025, 16, 203. https://doi.org/10.3390/microbiolres16090203
Abed AN, Mnif B. Emerging Resistance in Klebsiella pneumoniae: CTX-M Prevalence, Biofilm Formation, and Efficacy of Platanus orientalis Extract. Microbiology Research. 2025; 16(9):203. https://doi.org/10.3390/microbiolres16090203
Chicago/Turabian StyleAbed, Ahmed Najm, and Basma Mnif. 2025. "Emerging Resistance in Klebsiella pneumoniae: CTX-M Prevalence, Biofilm Formation, and Efficacy of Platanus orientalis Extract" Microbiology Research 16, no. 9: 203. https://doi.org/10.3390/microbiolres16090203
APA StyleAbed, A. N., & Mnif, B. (2025). Emerging Resistance in Klebsiella pneumoniae: CTX-M Prevalence, Biofilm Formation, and Efficacy of Platanus orientalis Extract. Microbiology Research, 16(9), 203. https://doi.org/10.3390/microbiolres16090203

